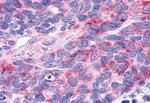
RORA Antibody in Immunohistochemistry (Paraffin) (IHC (P))

Search
Invitrogen
RORA Polyclonal Antibody
{{$productOrderCtrl.translations['antibody.pdp.commerceCard.promotion.promotions']}}
{{$productOrderCtrl.translations['antibody.pdp.commerceCard.promotion.viewpromo']}}
{{$productOrderCtrl.translations['antibody.pdp.commerceCard.promotion.promocode']}}: {{promo.promoCode}} {{promo.promoTitle}} {{promo.promoDescription}}. {{$productOrderCtrl.translations['antibody.pdp.commerceCard.promotion.learnmore']}}
产品信息
PA5-34159
种属反应
宿主/亚型
分类
类型
抗原
偶联物
形式
浓度
规格
纯化类型
保存液
内含物
保存条件
运输条件
RRID
靶标信息
RORA is a receptor for retinoic acid belonging to the NR1 subfamily of nuclear hormone receptors with a nuclear receptor DNA binding domain. RORA binds either as a monomer or as a homodimer to the retinoic acid response element and thus regulates gene expression and also controls cell function. Though the exact function of RORA is yet unknown, it interacts with NM23-2, a nucleoside diphosphate kinase involved in organogenesis and differentiation, NM23-1, the product of a tumor metastasis suppressor candidate gene, CDK7, NCOA3 and NCOA6 coactivators. It is found to express in mesenchymal stem cells derived from bone marrow and are known to act by direct modulation of a bone matrix component. It is widely expressed in most of the tissues. Chromosomal aberrations involving RORA may be a cause of acute promyelocytic leukemia (APL).
仅用于科研。不用于诊断过程。未经明确授权不得转售。
篇参考文献 (0)
生物信息学
蛋白别名: Nuclear receptor ROR-alpha; Nuclear receptor RZR-alpha; Nuclear receptor subfamily 1 group F member 1; putative new variant; RAR-related orphan nuclear receptor alpha; RAR-related orphan receptor A; RAR-related orphan receptor alpha; retinoic acid receptor-related orphan receptor alpha; retinoid-related orphan receptor alpha; Retinoid-related orphan receptor-alpha; ROR Alpha; ROR-alpha; Roralpha; transcription factor RZR-alpha
基因别名: 9530021D13Rik; IDDECA; nmf267; NR1F1; ROR1; ROR2; ROR3; RORA; RORa1; RORalpha; RZR-ALPHA; RZRA; sg; staggerer; tmgc26
UniProt ID: (Human) P35398, (Mouse) P51448
Entrez Gene ID: (Dog) 478328, (Horse) 100147460, (Bovine) 535597, (Rabbit) 100357159, (Human) 6095, (Pig) 100156637, (Rat) 300807, (Mouse) 19883